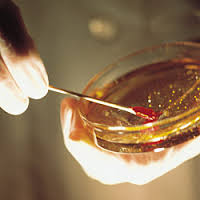

LUKA FARAJ BELUM SEMBUH
“Assalamualaikum doctor Zubaidi. Saya mengalami bengkak pada kelenjar limfa di bahagian celah peha. Hal ini disebabkan oleh ulcer dalam vagina yg telah terkoyak semasa hubungan kelamin. Untuk makluman doctor sy telah berkahwin. Saya telah diberikan ubat antibiotik cefamyine, ubat bengkak papase, serta gel gengigel untuk di sapu pada ulcer yg terdapat dlm mulut dan dalam vagina.
Ubat yang diberikan adalah untuk 7hari sahaja. Sekiranya ubat telah habis dan bengkak masih belum reda..perlukah saya berjumpa dengan doctor semula?
Saya juga mengalami demam yang biasanya lebih terasa dalan waktu malam. Saya juga menggunakan alternatif lain untuk mengurangkan bengkak tersebut menggunakan kaedah bertungku @tuam dan melekat pelekat herba pada bahagian yang bengkak.
Maklum balas dari pihak doctor sangat saya hargai. Terima kasih.”
WA ALAIKUM MUS SALAM
Bengkakan pada kelenjar limfa di bahagian celah peha menunjukkan ada jangkitan kuman pada bahagian sekitar kemaluan, peha itu sendiri, betis dan kaki.
Dalam kes puan, bengkakan kelenjar limfa disebabkan oleh luka pada faraj, yang berlaku semasa hubungan kelamin. Luka sebegini berlaku apabila si isteri belum lagi bersedia menerima kemasukan zakar suami. Kebiasaannya faraj akan mengeluarkan lendiran bagi memudahkan kemasukan zakar. Ini mengelakkan geseran kasar dan akhirnya lapisan mukosa pada faraj terkoyak.
Luka dalam faraj memang agak sukar sembuh berbanding dengan luka pada kulit kerana kedudukannya di dalam lipatan. Ini menyebabkan ia sentiasa lembap dan merangsangkan pembiakan kuman.
Tanda luka faraj bertambah teruk apabila luka itu mengeluarkan nanah, berbau busuk dan menyebabkan rasa pedih Walau bagaimana pun ada luka yang tidak menyebabkan rasa sakit. Selain itu apabila puan berasa demam, ia menandakan luka itu sudah dijangkitai kuman bakteria.
Saya selalunya memeriksa keadaan pesakit kerana jika pesakit mengalami masalah kesihatan, luka akan menjadi lambat sembuh, terutama pesakit diabetes mellitus yang tidak terkawal gulanya.
Selain itu saya akan memeriksa darah, kerana ada luka faraj yang disebabkan oleh masalah penyakit kelamin. Saya tidak menuduh suami puan sebagai suami yang nakal, namun apa-apa saja boleh berlaku. Dengan melakukan pemeriksaan darah untuk penyakit kelamin, kita dapat merawat luka tersebut dengan baik dan sempurna jika ia berlaku.
Doktor juga boleh mengambil sampel lendiran dari luka untuk dihantar untuk pemeriksaan makmal bagi melihat antibiotic mana yang lebih sesuai. Prosedur ini dinamakan “culture and sensivity”. Apabila keputusan prosedur ini telah diketahui, kita akan tahu antibiotic mana yang sesuai dan berkesan untuk luka tersebut.
Untuk menggalakkan proses penyembuhan, saya mencadangkan puan mengambil suplemen (selain antibiotic) yang mempunyai banyak antioksida seperti ekstrak kacip Fatimah, vitamin C dan E.
Puan boleh melakukan rendaman, dengan duduk di dalam basin besar yang mengandungi air suam yang dicampurkan dengan antiseptic (boleh didapati dari farmasi).
Minum air secukupnya bagi meningkatkan system daya tahan.
Wallahu a’lam.
IKLAN
Bagi wanita yang mengalami masalah kitaran haid yang tidak menentu, dan bagi wanita yang baru melahirkan anak, saya mencadangkan suplemen, selain dari vitamin C dan E. Boleh dapatkan produk Kacip Fatimah keluaran UTM di http://needsvenue.com.my
Bagi individu yang mengalami kekeringan kulit, terutamanya eczema saya mencadangkan cream Labicea Revitalizing Moisturizer. Info lanjut di https://www.facebook.com/Labicea-Revitalizing-Moisturizer-486696818067490/
Untuk pembelian menggunakan kad kredit sila klik di bawah:

Dr Zubaidi Hj Ahmad Menulis Perkongsian Pengetahuan dan Pengalaman